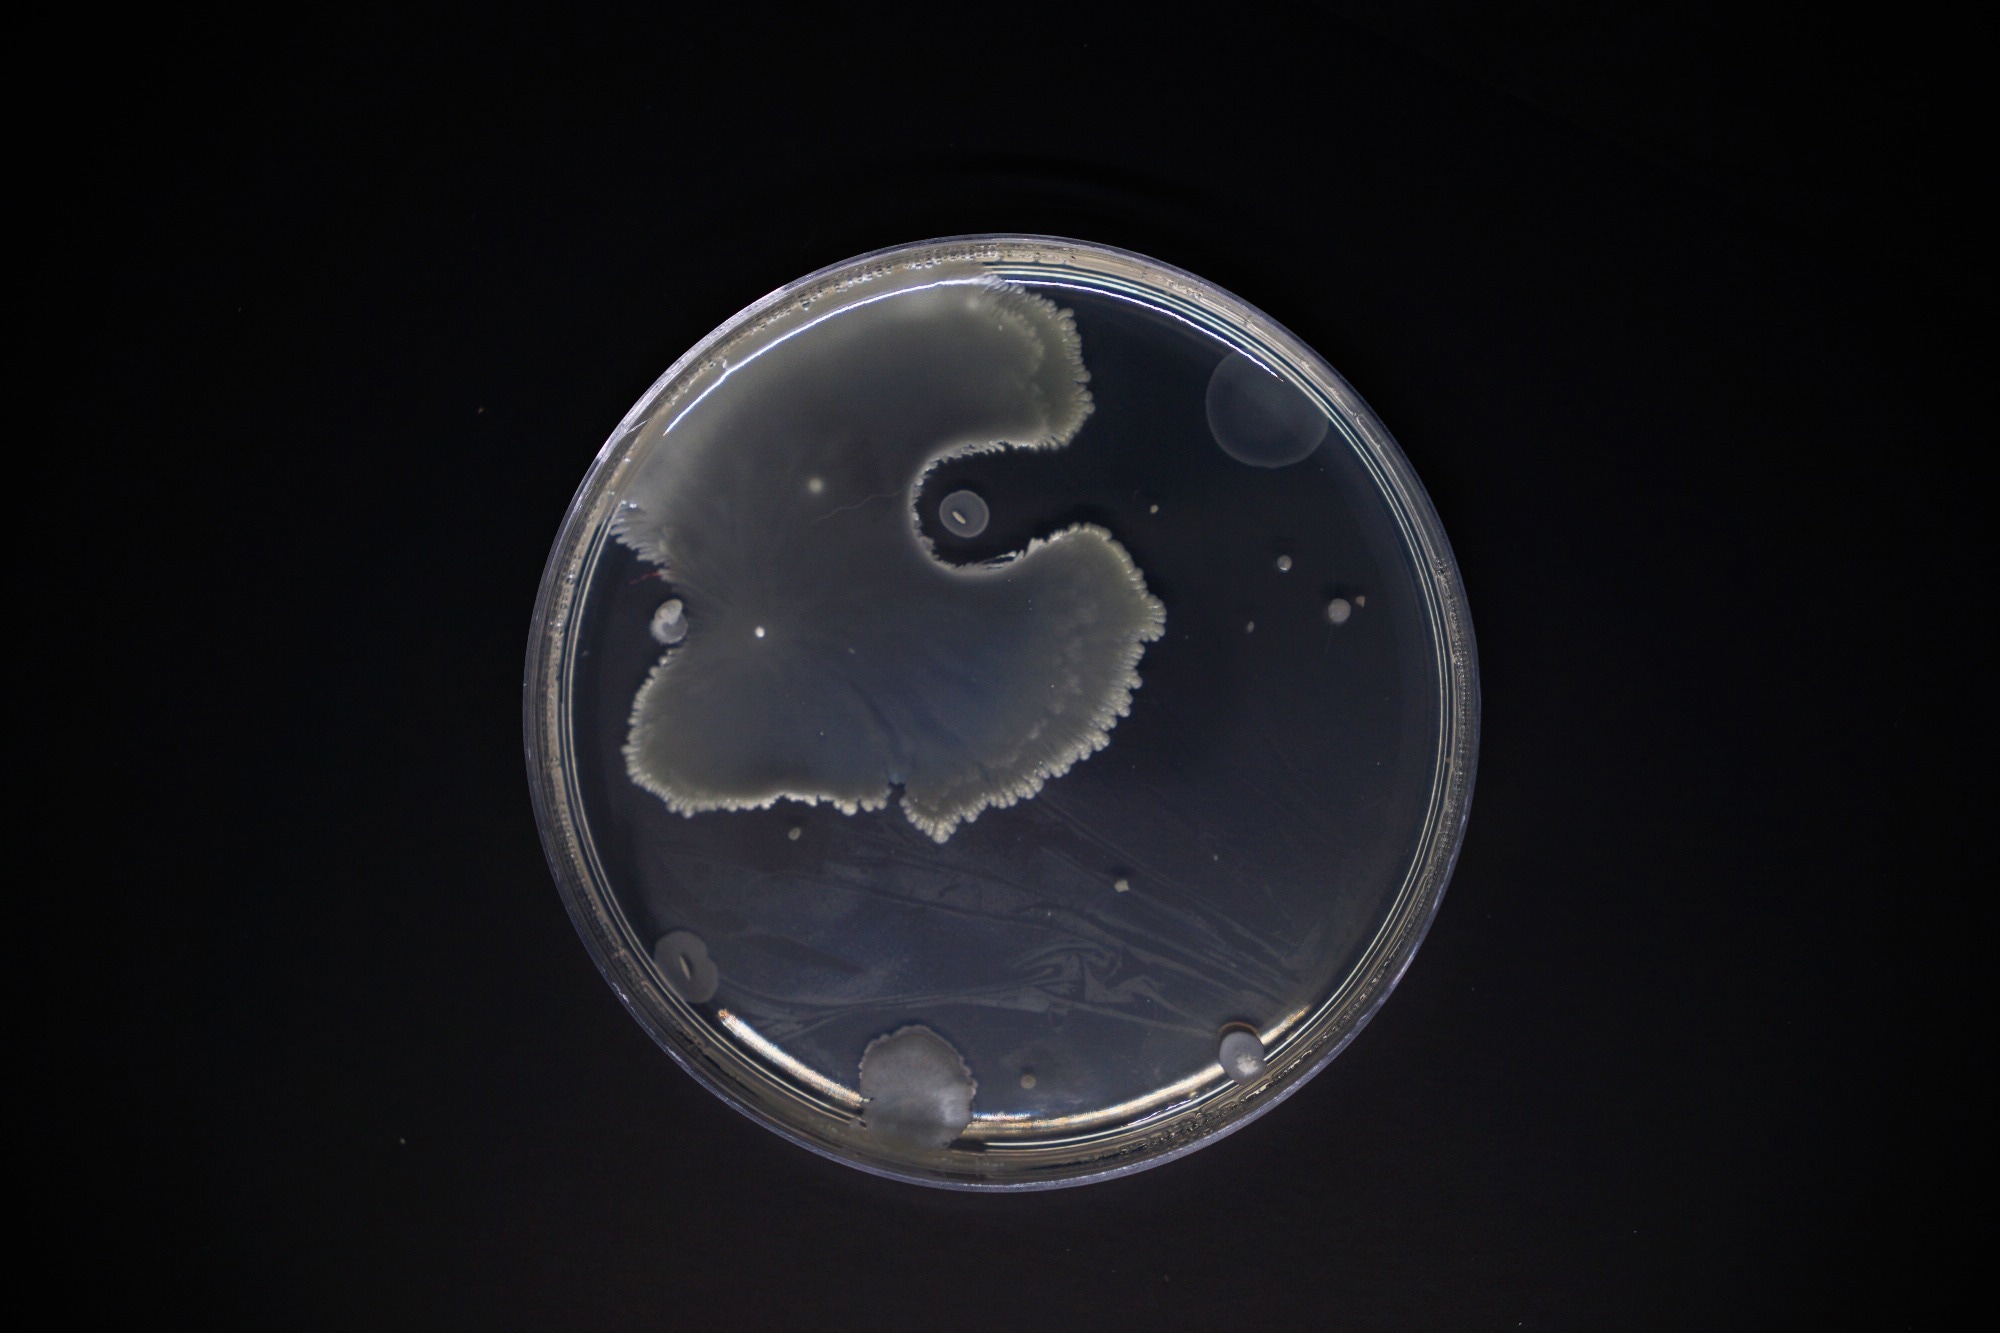

A recent study published in npj | Biofilms and Microbiomes explored biofilm maturation and dispersal dynamics in Bacillus subtilis using solid-state nuclear magnetic resonance (ssNMR) spectroscopy. Researchers examined compositional and structural changes in biofilms over time, providing valuable insights into microbial behavior.
Image Credit: Esther Cortez/Shutterstock.com
Advancements in Biofilm Analysis Technology
Biofilms are complex microbial communities that adhere to surfaces and are enclosed in a self-produced extracellular polymeric substance (EPS) matrix. Understanding their formation, stability, and dispersal is crucial due to their impact in medical and industrial settings.
ssNMR has emerged as a valuable technique for analyzing biofilm composition and structural integrity. It offers an in situ approach to studying biofilm complexity and matrix interactions.
Exploring Biofilm Maturation and Dispersal
This study addressed key gaps in biofilm research by quantitatively analyzing the structural components of Bacillus subtilis biofilms over five days. Biofilm pellicles were cultivated in a modified MSgg medium, which provided increased carbon and nitrogen availability while reducing buffering agents. This modification accelerated biofilm formation and allowed researchers to track compositional changes effectively.
B. subtilis was initially grown in Luria-Bertani broth before being transferred to the modified MSgg medium. Isotope labeling was performed using 13C-labeled glycerol to enhance NMR sensitivity. Samples were collected at specific intervals for analysis.
The study used ssNMR to examine biofilm composition and molecular dynamics. One-dimensional (1D) and two-dimensional (2D) NMR techniques provided insights into interactions between mobile and rigid phases. These methods helped characterize the molecular behavior of biofilm and their contributions to overall biofilm architecture.
Key Findings: Structural and Compositional Insights
The results highlighted significant temporal changes in biofilm composition. Biofilm maturation occurred within the first 48 hours, followed by a substantial degradation phase over the next 72 hours. Notably, proteins degraded before exopolysaccharides, with protein levels declining by day three and carbohydrate levels decreasing by day four.
Distinct biofilm development phases were identified, characterized by shifts in biomass accumulation and dispersal. Biomass peaked on day two, followed by a decline linked to glycerol depletion in the surrounding medium, which triggered dispersal.
The biofilm development process was categorized into three phases: maturation, rapid decay, and slow decay.
As the biofilm dispersed, the mobile phase became increasingly rigid, indicating that mobile components degraded more rapidly than the stable, rigid phase. Exopolysaccharide sugar analysis suggested the presence of multiple polysaccharide types within the biofilm matrix. Biofilm degradation occurred asynchronously, with proteins degrading faster than exopolysaccharides, likely due to their proximity to enzyme-secreting cells. The mobile phase accounted for 76 % to 91 % of the total biomass and exhibited significant compositional shifts, particularly a sharp decline in carbohydrates during dispersal. More than 90 % of carbon biomass in mature biofilms existed in a mobile state, which decreased as the rigid phase increased.
Monosaccharide analysis revealed that glucose-based sugars were retained within the biofilm matrix, whereas galactose-based sugars were more readily released into the surrounding medium. This suggests that glucose-rich polysaccharides contribute to structural integrity, while galactose-based sugars may play a role in biofilm signaling. A sharp rise in aliphatic carbon signals on day four correlated with increased biosurfactant production, likely facilitating cell dispersal.
Applications and Implications
This research has broad implications across various fields. Understanding biofilm maturation and dispersal is essential for controlling harmful biofilms in medical environments, where they contribute to chronic infections and antibiotic resistance. These insights could guide targeted interventions to disrupt pathogenic biofilms while preserving beneficial microbial communities.
In industrial settings, knowledge of biofilm behavior can enhance sanitation protocols in high-risk environments, such as water treatment facilities and food processing plants. Additionally, these findings may support agricultural applications by optimizing biofilm-based biocontrol agents and improving beneficial microbial interactions that promote plant health.
Further research should explore the broader implications of biofilm-environment interactions and refine strategies for biofilm management across diverse sectors. Investigating external factors that influence biofilm stability and dispersal could help develop innovative solutions to biofilm-related challenges in medicine, industry, agriculture, and wastewater treatment.
Journal Reference
Xue, Y. (2025). Time-resolved compositional and dynamics analysis of biofilm maturation and dispersal via solid-state NMR spectroscopy. npj Biofilms Microbiomes. DOI: 10.1038/s41522-025-00655-4, https://www.nature.com/articles/s41522-025-00655-4
Disclaimer: The views expressed here are those of the author expressed in their private capacity and do not necessarily represent the views of AZoM.com Limited T/A AZoNetwork the owner and operator of this website. This disclaimer forms part of the Terms and conditions of use of this website.